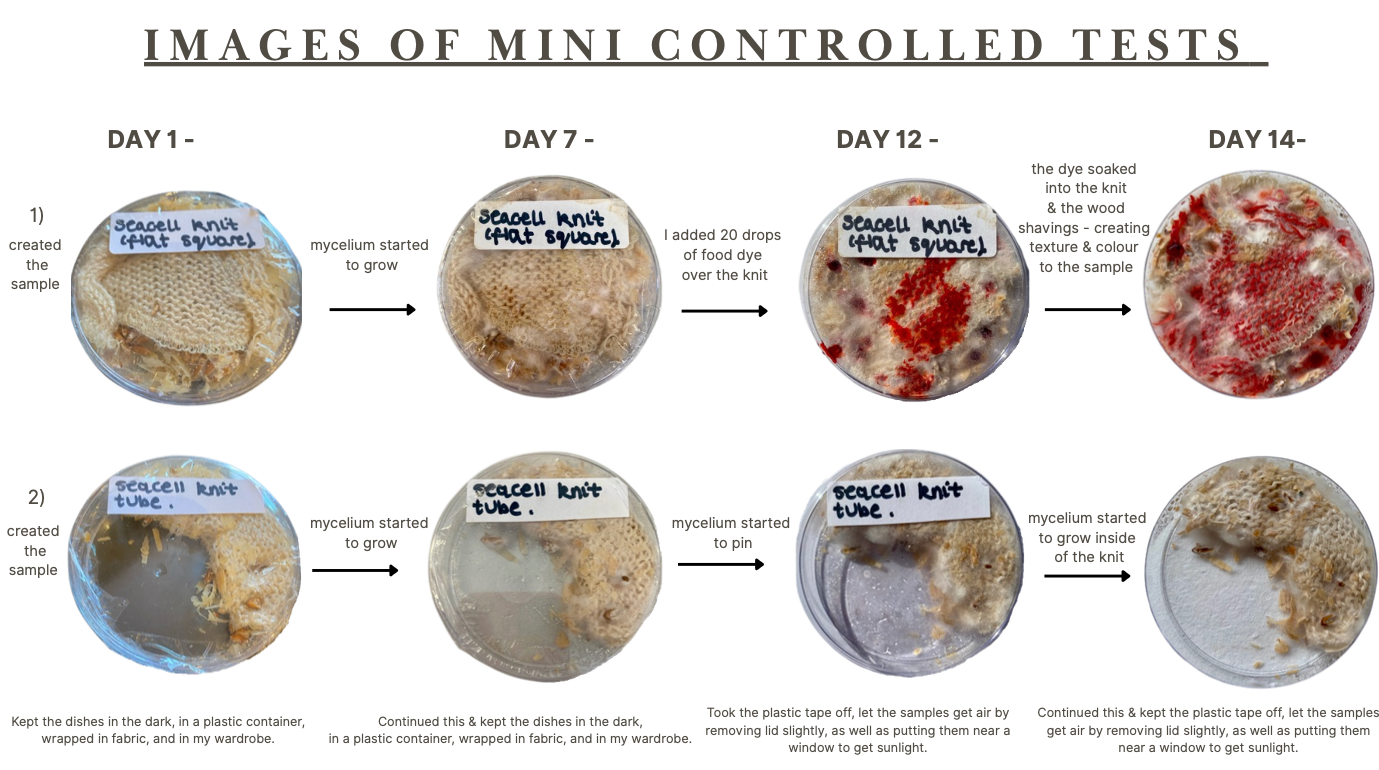
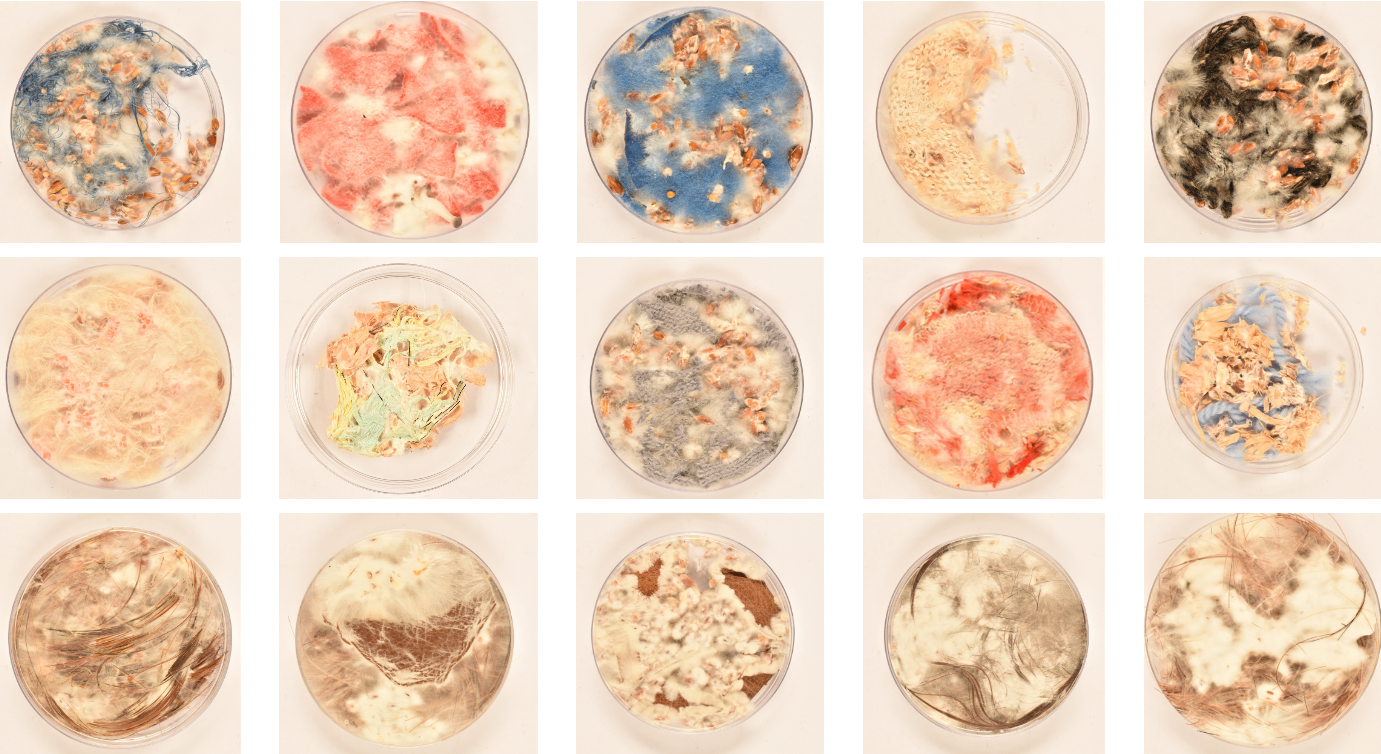

Merryn Rush
Textile Design BA
Loughborough University
Graduates: 2025
Specialisms: Textiles / Sustainable Fashion/Textiles / Textile Innovation/Textile Art
My location: London, United Kingdom


Merryn Rush

First Name: Merryn
Last Name: Rush
University / College: Loughborough University
Course / Program: Textile Design BA
Graduates: 2025
Specialisms: Textiles / Sustainable Fashion/Textiles / Textile Innovation/Textile Art
My Location: London, United Kingdom
Website: Click To See Website
About
"Earththreads - the living thread"
'Earththreads- The Living Thread' is centred around the exploration of mycelium, which is a root-like fungus that has been grown from barleycorn. The project delves into how to grow a sustainable & biodegradable material using knitting and bonding of the mycelium through my project process. It emphasises on longevity and explores that there are numerous opportunities to grow mycelium from not only barleycorn, but other protein- based sources. The key question throughout this is "How many different ways can I embed mycelium barleycorn into a material?". The aim of the project is to work with natural and not against it, by being guided and driven solely by the mycelium. The mycelium turned the project into a material development and research project on its own. Although the project altered slightly depending on the journey the mycelium took me on, one of the main areas of focus was exploring how knit could be a carrier for mycelium, and the concept of using mycelium as the vehicle for the barley seeds, and how this could be integrated into knit to create a fabric/ material. Knit was chosen to be the surface that the mycelium will grow into, as the structure is loose and makes the embedding of the barley seeds easier. The knitting machine also allowed for chunkier yarns to be easily knitted into a structure. The use of mycelium responds to issues of not having enough biodegradable and eco-friendly materials in the textiles industry, ranging from fashion to interiors. This project aims to highlight issues of using the earth and plants to help us tackle issues around the environment. The intensity and sheer vast of fast fashion brands that now exist cause too much damage during many different phases of a materials lifecycle. This varies from the production and water waste it creates, to the greenhouse gases released, and to the landfill that it goes to when binned. This is Sonya short list of the cycle materials and fabrics go through, throughout its life. By exploring mycelium, using knit, I have developed different structural examples of how mycelium can be grown onto a fabric to create natural materials and fibre bonding, along with the health benefits mycelium produces. For example, it is an air purifier and great insulator. suggesting the possibilities that mycelium could be a replacement for stitching , or a purifier for clothes; allowing you to breathe cleaner air, alongside being biodegradable and can be buried back into the ground afterwards with no consequences. This project aims to explain the benefits, as well as exploring possible applications it could be used in; through the use of experimentation and exploration. The key findings are documented to explain and allow for further development through the use of yarn and knitting. Knit was explored in tow different ways; the first one being through the use of a manual hand knitting machine, and the second is the use of a Shima digital knitting machine, to compare the two together.
Competitions